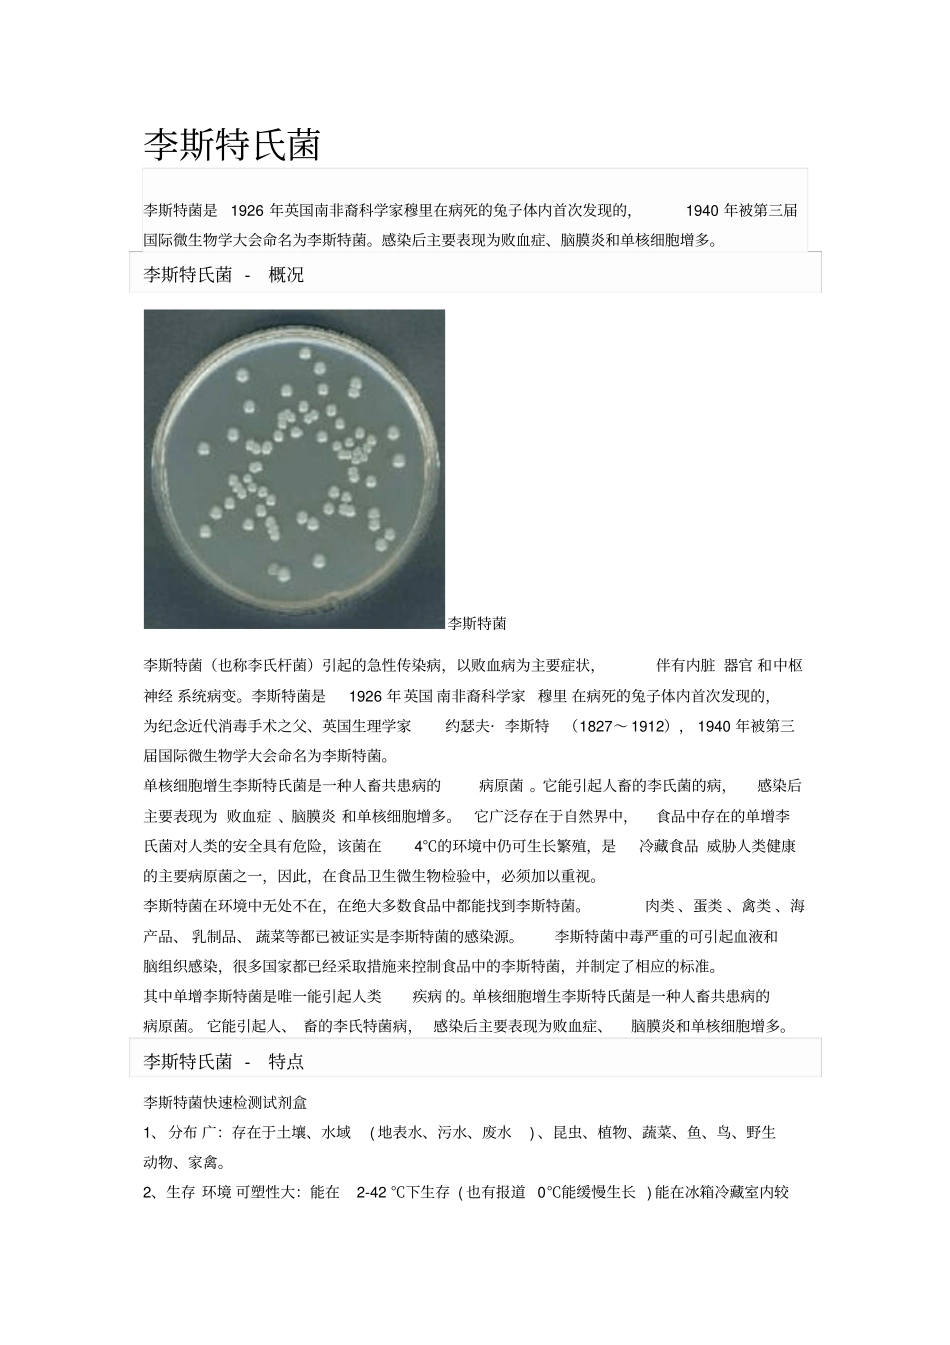
李斯特菌检验应用_第1页

李斯特氏菌李斯特菌是1926 年英国南非裔科学家穆里在病死的兔子体内首次发现的,1940 年被第三届国际微生物学大会命名为李斯特菌
感染后主要表现为败血症、脑膜炎和单核细胞增多
李斯特氏菌 - 概况李斯特菌李斯特菌(也称李氏杆菌)引起的急性传染病,以败血病为主要症状,伴有内脏 器官 和中枢神经 系统病变
李斯特菌是1926 年英国 南非裔科学家 穆里 在病死的兔子体内首次发现的,为纪念近代消毒手术之父、英国生理学家约瑟夫· 李斯特(1827~ 1912), 1940 年被第三届国际微生物学大会命名为李斯特菌
单核细胞增生李斯特氏菌是一种人畜共患病的病原菌
它能引起人畜的李氏菌的病,感染后主要表现为 败血症 、脑膜炎 和单核细胞增多
它广泛存在于自然界中,食品中存在的单增李氏菌对人类的安全具有危险,该菌在4℃的环境中仍可生长繁殖,是冷藏食品 威胁人类健康的主要病原菌之一,因此,在食品卫生微生物检验中,必须加以重视
李斯特菌在环境中无处不在,在绝大多数食品中都能找到李斯特菌
肉类 、蛋类 、禽类 、海产品、 乳制品、 蔬菜等都已被证实是李斯特菌的感染源
李斯特菌中毒严重的可引起血液和脑组织感染,很多国家都已经采取措施来控制食品中的李斯特菌,并制定了相应的标准
其中单增李斯特菌是唯一能引起人类疾病 的
单核细胞增生李斯特氏菌是一种人畜共患病的病原菌
它能引起人、 畜的李氏特菌病, 感染后主要表现为败血症、脑膜炎和单核细胞增多
李斯特氏菌 - 特点李斯特菌快速检测试剂盒1、分布 广:存在于土壤、水域( 地表水、污水、废水) 、昆虫、植物、蔬菜、鱼、鸟、野生动物、家禽
2、生存 环境 可塑性大:能在2-42 ℃下生存 ( 也有报道 0℃能缓慢生长 ) 能在冰箱冷藏室内较长时间生长繁殖
3、适应 范围 大:酸性、碱性条件下都适应
4、带菌较高的 食品 有:牛奶和乳制品;肉类( 特别